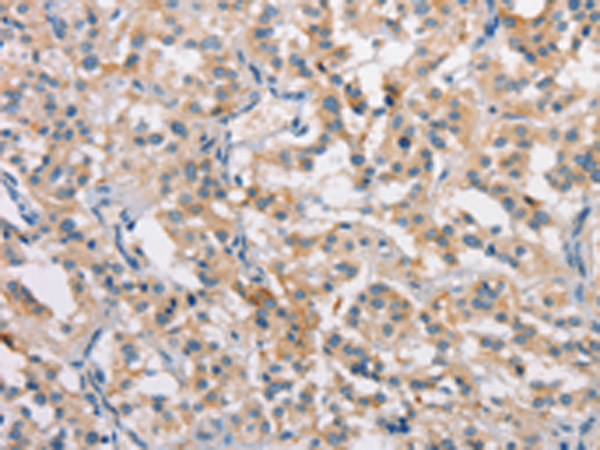

中文名稱:兔抗CLDN11多克隆抗體
|
Background: |
This gene encodes a member of the claudin family. Claudins are integral membrane proteins and components of tight junction strands. Tight junction strands serve as a physical barrier to prevent solutes and water from passing freely through the paracellular space between epithelial or endothelial cell sheets, and also play critical roles in maintaining cell polarity and signal transductions. The protein encoded by this gene is a major component of central nervous system (CNS) myelin and plays an important role in regulating proliferation and migration of oligodendrocytes. Mouse studies showed that the gene deficiency results in deafness and loss of the Sertoli cell epithelial phenotype in the testis. |
|
Applications: |
ELISA, IHC |
|
Name of antibody: |
CLDN11 |
|
Immunogen: |
Synthetic peptide of human CLDN11 |
|
Full name: |
claudin 11 |
|
Synonyms: |
OSP; OTM |
|
SwissProt: |
O75508 |
|
ELISA Recommended dilution: |
1000-2000 |
|
IHC positive control: |
Human thyroid cancer and Human gastric cancer |
|
IHC Recommend dilution: |
15-50 |
購物車
購物車 幫助
幫助
 021-54845833/15800441009
021-54845833/15800441009
